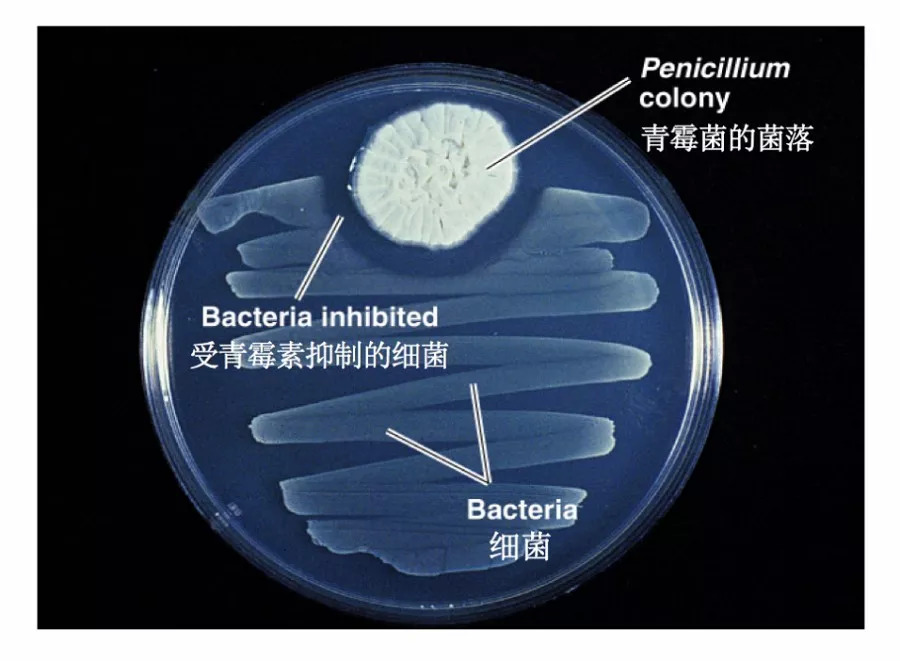

作者: 黄佩

图片来源http://www.health.state.mn.us
一听到头孢,你肯定知道这是一种抗生素。对于感冒这种小病,我们经常不去医院,自己去药房买一盒感冒药、一盒头孢或者所谓消炎药对付过去。但是现在,药房已经被限制售卖抗生素。你可能会问,为啥这么难买?不就一盒抗生素。
抗生素并没有你想象得那么简单,不正确使用可能会对我们的健康造成隐患。今天,我们就以抗生素为题向大家作简单的科普。
抗生素的发现:医学界的历史性变革
天然的抗生素是细菌、霉菌或其它微生物为了抵抗病原体或其它活性细胞而产生的代谢产物。在临床上抗生素专门用于治疗细菌(如金黄色葡萄球菌,链球菌或大肠杆菌)引起的感染,杀死细菌或防止其繁殖和生长,对人体细胞不造成直接伤害。
第一种发现并用于疾病治疗的天然抗生素药物是青霉素。恰是90年前的1928年,Alexander Fleming偶然发现在葡萄球菌培养皿上生长出的霉菌限制了原有葡萄球菌的生长,“葡萄球菌菌落变得透明并且被溶解”。他认为是青霉菌产生了某种化学物质,分泌到培养基里抑制了细菌的生长。进一步的实验证明这种活性物质的确存在,将其命名为“青霉素(Penicillin)”。
图1 细菌受到青霉素抑制在青霉菌菌落周围形成透明环(来源http://www.pharmamicroresources.com)
随后,另外两位科学家,澳大利亚人Howard Florey和 Ernst Chain进一步开发了青霉素,将其作为药物生产。1942年,第一例患者在美国接受链球菌败血症治疗并获得成功。在第二次世界大战期间,青霉素帮助减少了部队的死亡人数和伤员的截肢次数。
青霉素的发现是医学史上最重要的进步之一。它降低了传染病的发病率和严重程度,以前不可治愈的疾病,如肺炎,猩红热,肺结核和感染都被消灭,彻底改变了现代医学。也因此,Alexander和其他两位科学家于1945年共同被授予诺贝尔医学奖。

图2 青霉素的发现者-Alexander Fleming
(来源http://otecorporation.com)
抗生素的发现:医学界的历史性变革
大多数喉咙痛,咳嗽和感冒,流感或急性鼻窦炎来源于病毒(不是细菌),图3给出了细菌和病毒的形状对比,细菌呈现出杆状,线状等等,而病毒则更像是多面体形状。二者除了形态大小差异较大,在生物分类学上也不能等同。通常情况下,人体自身的免疫系统会启动并对抗病毒,换句话说,不用吃药,靠着自己的抵抗力就可以治愈感冒病毒。

图3 细菌和病毒的形态对比
(图片来源https://www.news-medical.net)
抗生素起作用主要是针对细菌,不能抵抗任何病毒感染。比如青霉素类和头孢类的抗生素主要抑制细菌的细胞壁生成,从而细菌破裂死亡。所以在没有任何细菌感染的症状下,服用头孢等抗生素药物往往不能起到作用,反而可能会提高抗生素耐药性,影响以后细菌感染类疾病治疗的抗生素选择,增加治病的时间和经济成本。

图片来源:https://www.deviantart.com
什么是抗生素耐药性?在一定环境条件下使用抗生素,绝大多数细菌会被杀死从而达到治病目的,但仍然会有细菌存活下来,我们认为存活下来的细菌能抵抗这类抗生素,将它们称为耐药型细菌,而这种现象则被称为细菌的抗生素耐药性。
造成抗生素耐药性的原因很多。其中最重要的原因,是新药研发一直没有跟上细菌耐药的步伐。细菌耐药基因的种类和数量增长速度飞快,而现阶段抗生素的新药开发鲜有新的抗生素的发现,仅仅是现有抗生素的轻微改造。
另一个原因是普通民众滥用误用抗生素。抗生素通常定价便宜,不需要处方就可以轻易买到,而等到医院就医时,医生就不得不选择药效更强的抗生素,更容易导致病菌产生更强的抗药性。
青霉素问世后,抗生素成了人类战胜病菌的神奇武器。虽然新的抗生素层出不穷,但是奈何不了耐药菌越来越多,耐药菌的传播令人担忧。
据美国疾病控制与预防中心估计,仅在美国每年就有大约23,000人死于抗生素耐药性感染。英国卫生公共部门报道称,如果现状没有改变,到2050年抗生素耐药性将可能导致全世界1000万人死亡。前世界卫生组织总干事陈冯富珍博士将抗生素耐药性描述为“当今全球公共卫生面临的最大挑战之一”。

抗生素耐药性的全球损失预测
(来源:https://blog.sekisuidiagnostics.com)
抗生素耐药性现象在我们国家比较严重,已经引起了政府和社会高度重视。国家卫生部与2012年8月1日颁布了针对医疗机构使用抗生素的标准和规定,并出台一些政策、指南和限购令来规范抗生素的市场售卖。大家也逐渐发现抗生素药管制越发严格,不允许个人购买。尽管如此,我国的抗生素滥用现状仍然堪忧。
抗生素应该这样用
关于感冒生病了是否需要服用抗生素的问题,我们的回答是,抗生素不能消炎,不可当做消炎药服用,建议去正规医院就医,遵从医生的治疗意见,针对具体情况选用适宜的抗菌药物、采用适当的剂量和疗程。与此同时,为了自身和家人的健康,我们每个人都应该了解抗生素使用的相关知识,避免自主用药时盲目使用抗生素。应注意以下问题:
第一
是否有细菌感染的病症。
如果没有,不要使用抗生素。常见的感冒流感喉咙痛,都不是细菌感染造成的,不需要服用抗生素药物。
第二
辨别是否是抗生素药物。
抗生素是西药,命名有一定规律。药名词头带“头孢”“磺胺”的一般都是抗生素,比如头孢克肟,磺胺甲恶唑,词尾带“霉素”或者“沙星”的也都是抗生素。比如“红霉素”“诺氟沙星”等。另外看药品的适应症和病理作用,如果是用来抗菌,杀菌或者抑菌的都可能是抗生素。
第三
注意抗生素药物的使用剂量。
遵照药品说明或者医嘱的剂量服用,不过度过量服用。
第四
是否对抗生素过敏。
如果是针剂注射,请提前做好皮试。口服用药应注意避开过敏的抗生素药物。
参考文献
胡燕等, 我国抗生素滥用现状、原因及对策探讨. 中国社会医学杂志. 2013.4(30)2:128-129.
http://www.abc.net.au/science/slab/antibiotics/resistance.ht
https://www.drugs.com/article/antibiotics.html
http://www.cumc.columbia.edu/psjournal/archive/winter-2005/drug.html
百度文库及百度百科等
(本文中标明来源的图片均已获得授权)
出品:科普中国
制作:中国科学院上海植物生物学逆境研究中心 黄佩
监制:中国科学院计算机网络信息中心
本文来源于“中国科普博览”公众号(kepubolan),转载请注明公众号出处





